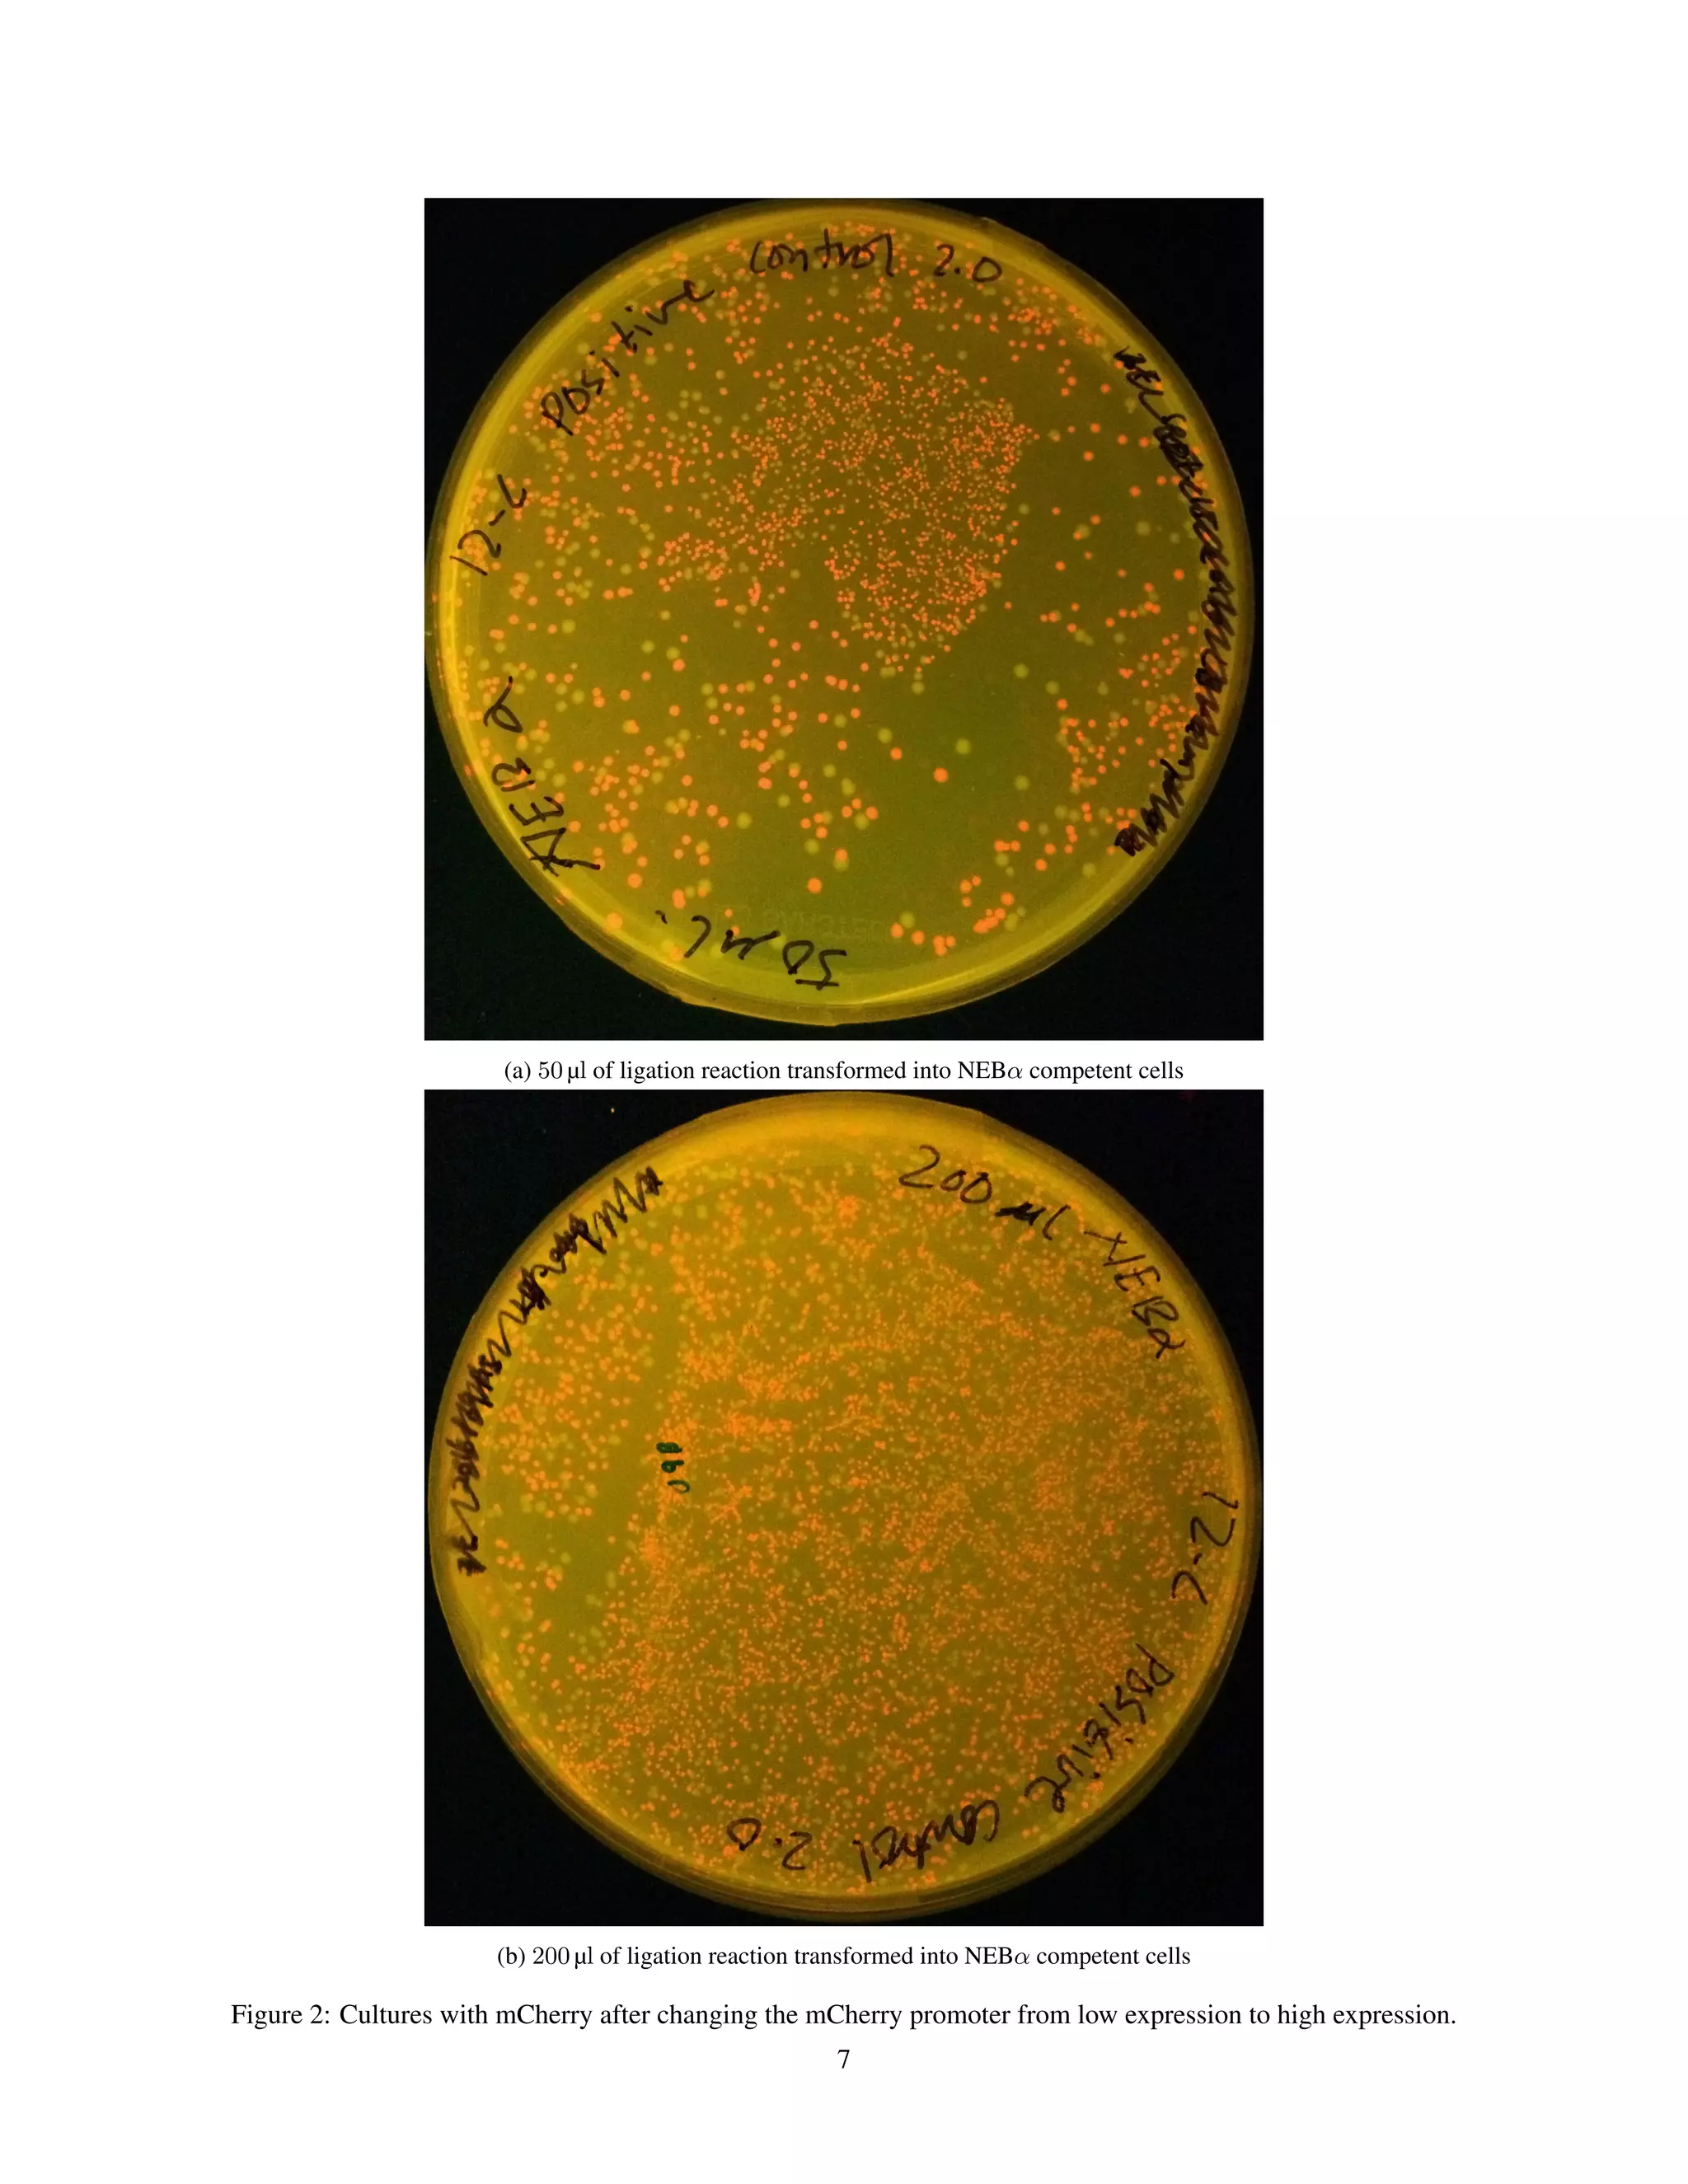
(a) 50 µl of ligation reaction transformed into NEBα competent cells
(b) 200 µl of ligation reaction transformed into NEBα competent cells
Figure 2: Cultures with mCherry after changing the mCherry promoter from low expression to high expression.
7

This document summarizes an experiment that aimed to change both the expression level and color of the fluorescent protein mCherry. The experiment involved:
1) Using restriction digestion and ligation to swap the promoter of mCherry from low to high expression, resulting in more mCherry colonies.
2) Attempting site-directed mutagenesis to change mCherry to mOrange but this was unsuccessful, as no orange colonies were observed.
3) Characterizing the fluorescence of mCherry, mOrange from a partner, and a negative control colony, finding mOrange emitted better at 500nm.

![References
[1] Z. Ding, B. Honda, A. Kim, J. Lum, S. MacLean, F. Pio, D. Sinclair, M. Syrzycka, P.J. Unrau,
S. Vlachos and S. Wang. Fall 2016 MBB308-3 Molecular Biology and Biochemistry Labora-
tory Manual. Department of Molecular Biology and Biochemistry. Simon Fraser University,
Burnaby, BC 2016.
14](https://image.slidesharecdn.com/93c1165e-b100-4246-a6c6-dfd621e1ace3-170109224436/75/Molecular_bilogy_lab_report_1-15-2048.jpg)